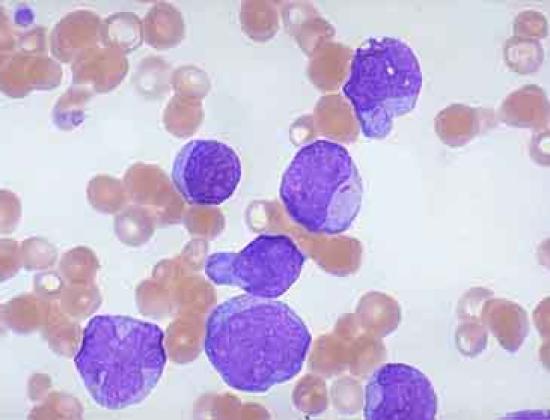

Ministar unutarnjih poslova Ranko Ostojić sinoć je operiran u zagrebačkoj bolnici Rebro.
Predsjednica Vlade Jadranka Kosor otvorila je danas rekonstruirane dijelove KBC-a Zagreb, vrijedne 57 milijuna kuna, od kojih je 37 milijuna osiguralo Ministarstvo zdravstva i socijalne skrbi dok je 20 milijuna osigurano iz kredita koji je podigao
Na konferenciji za medije službeno je predstavljen novootvoreni, moderan i gradski hotel „Rebro“. Hotel ima tri zvjezdice i kapacitet od 60 dvokrevetnih soba po cijeni od noćenja od 499,00 kn po sobi.
Udruga oboljelih od leukemije i limfoma ističe da je liječenje pacijenata znatno olakšano uvođenjem PET/CT pretrage te daje veliku potporu Poliklinici Medikol, HZZO-u i Ministarstvu zdravstva i socijalne skrbi jer omogućuju besplat
Pacijentima koji izvan Zagreba dolaze na pretrage i liječenje u KBC Zagreb i članovima njihovih obitelji krajem ožujka usluge smještaja trebao bi ponuditi novi hotel "Rebro", koji je u sklopu bolničkog kompleksa, a od rujna prošle godine u najmu je tvrtke "Hotel Partner".